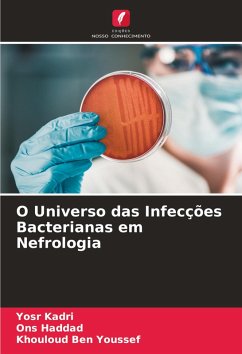

Infecções do trato urinário em mulheres grávidas
Versandkostenfrei!
Versandfertig in 6-10 Tagen
36,99 €
inkl. MwSt.

PAYBACK Punkte
18 °P sammeln!
Este livro apresenta uma descrição pormenorizada da bacteriúria sintomática e assintomática em mulheres grávidas de diferentes grupos etários e trimestres, com especial referência às bactérias associadas e à sua suscetibilidade a vários agentes antimicrobianos. Também lança luz sobre a resistência múltipla aos antibióticos em bactérias patogénicas e realça a importância do rastreio da urina para detetar bacteriúria significativa em mulheres grávidas.